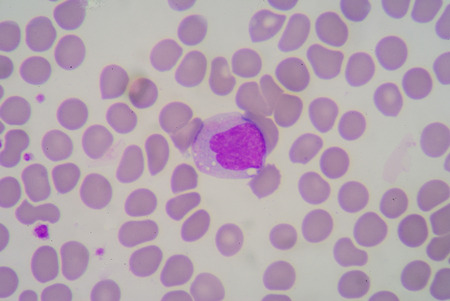
Blood smearの写真素材

写真素材 - Blood smear
キーワード
- bactericidal
- basophil
- biology
- blood
- bone marrow
- cell
- cytoplasm
- disease
- eosinophil
- granulated
- granules
- granulocyte
- health
- healthcare
- hematology
- human
- immune response
- immune system
- infection
- leukocyte
- lobed
- medical
- medicine
- microbiology
- microscope
- neutrophil
- nucleus
- on white
- organism
- pathology
- phagocytes
- antigen
類似作品
Immature white...
Blood smear wit...
view through th...
Abnormal red bl...
Malaria blood p...
glass and syrin...
Manual dissecti...
Red blood cell ...
White blood cel...
glass with bloo...
Chromosomes Hum...
in slide blood ...
White blood cel...
Blurred backgro...
Malaria blood p...
Red and white b...
Picture of acut...
Rows of microsc...
Neutrophil show...
stool specimen ...
Blood smear of ...
Blood film
Rows of microsc...
drop of blood o...
Normal red bloo...
Rows of microsc...
A microscope sl...
complete blood ...
White blood cel...
Chromosomes Hum...
Malaria blood p...
Blood slide
The study paras...
Blood smear on ...
Blood testing w...
microscope lens...
blood smear is ...
Smear of Gram's...
Laboratory
Hands in blue g...
Rows of microsc...
Medical laborat...
Blood pigcon un...
complete blood ...
Chronic myeloid...
Blood test anal...
blood test lab
White blood cel...
White blood cel...